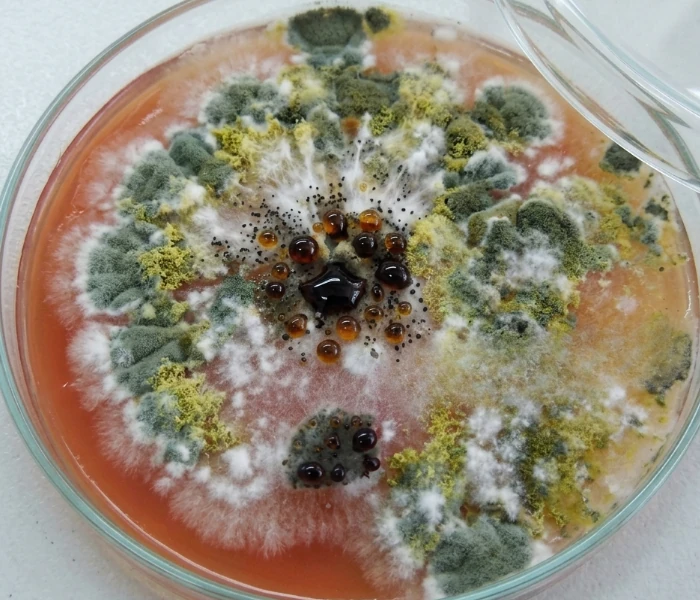
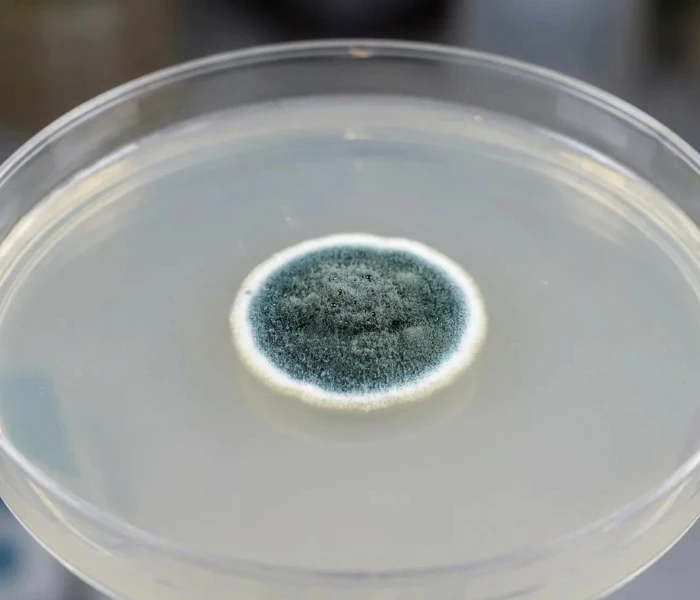
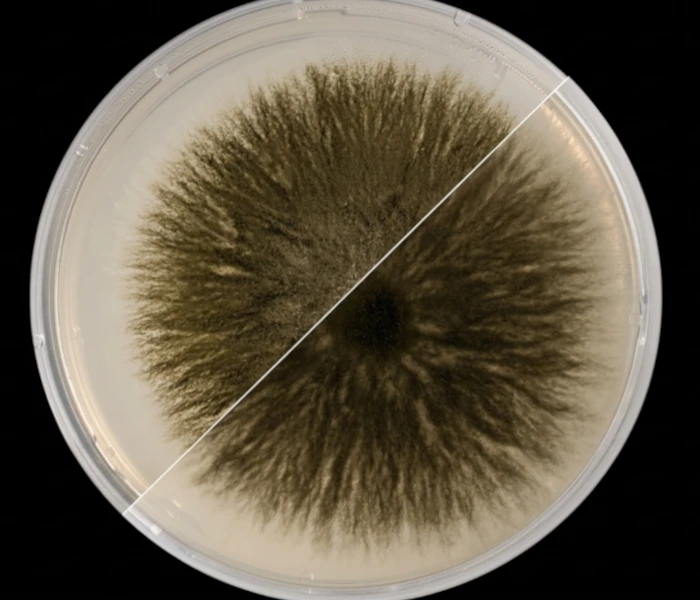
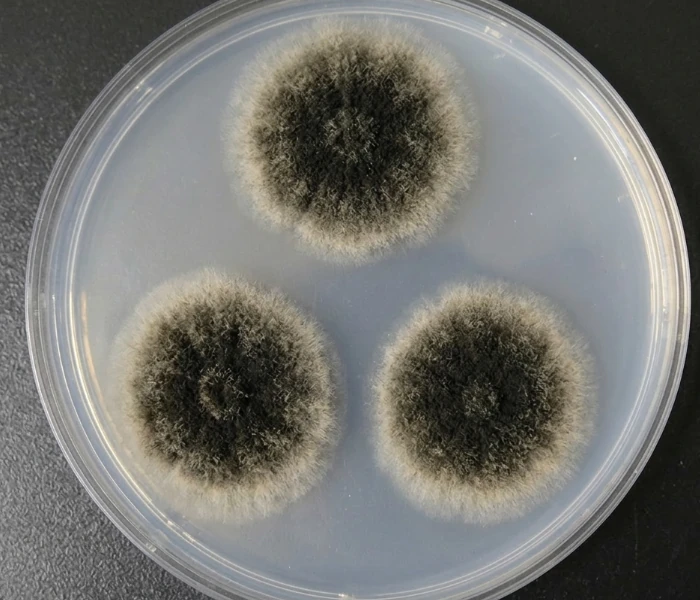
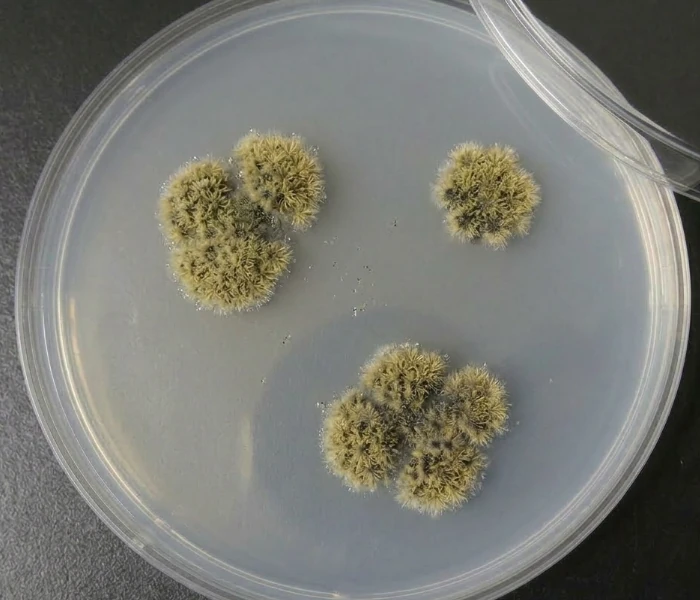
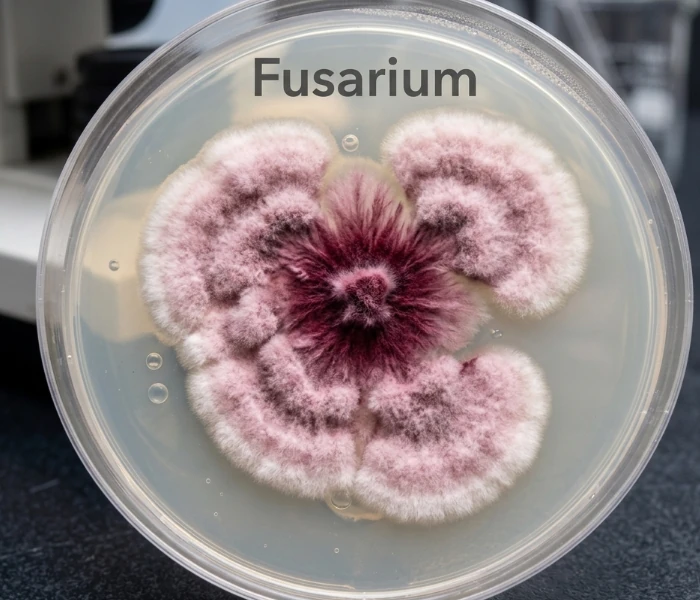

Mold exposure is one of the most overlooked indoor air quality problems affecting homes today. What starts as excess humidity, condensation, a small leak, or a damp crawl space can quietly spread behind walls, through HVAC systems, and into the air you breathe every day.
Research from organizations including the CDC, WHO, NIEHS, and EPA continues to connect damp indoor environments and mold exposure to respiratory irritation, allergy symptoms, asthma flare-ups, and other indoor air quality concerns. At the same time, uncontrolled moisture can slowly damage drywall, wood framing, insulation, and other structural materials throughout the home.
This guide was built to help homeowners understand how mold grows, where it hides, how exposure may affect health, and why moisture control is critical for long-term prevention. Every section below is grounded in published research, clinical findings, and real-world building science, not fear-based marketing or surface-level advice.
Contact Us Now for a Free Advanced Mold Testing if You Live in Long Island, Brooklyn, Queens, or The Bronx!
show signs of water damage or dampness
may be more sensitive to mold-related illness
with dozens linked to indoor health concerns
continues to connect mold exposure to respiratory and inflammatory issues
Before We Start — Common Myths
Only black mold is dangerous...
Bleach kills mold permanently...
You can smell mold if it's a problem....
Fungal Kingdom: Mold is neither bacterium nor virus — it is a multicellular fungus that digests organic material externally by secreting enzymes into its substrate before absorbing the broken-down nutrients.
Spore Mechanics: Mold reproduces by releasing spores measuring 1–10 microns in diameter. At that scale they are permanently airborne, traveling freely through ventilation systems and settling on every surface. No indoor environment can be rendered fully spore-free.
Mycotoxins: Certain species — most notably Stachybotrys chartarum, Aspergillus flavus, and Fusarium — produce mycotoxins as secondary metabolites. These are chemically distinct from spores and represent the primary mechanism behind systemic illness in heavily contaminated buildings.
Volatile Organic Compounds (VOCs): The characteristic musty odor of mold is produced by microbial volatile organic compounds, chiefly 3-methylfuran and geosmin. Their presence signals active metabolic growth and often indicates hidden colonization before any visible mold appears.
Growth Requirements: Mold requires a moisture threshold of approximately 70% relative humidity or direct water contact, an organic substrate, and a temperature between roughly 40°F and 100°F. Drywall paper, wood framing, cellulose insulation, and ceiling tiles are ideal substrates — they are organic, porous, and common.
Colonization Timeline: Water intrusion triggers visible colonization within 24–48 hours under favorable conditions. That window is the professional response threshold — remediation begun within it can prevent establishment; remediation delayed beyond it is containment.
The Amplification Cycle: Moisture enables growth, growth triggers spore release, spores travel through HVAC distribution, and new colonies establish throughout the structure — often far from the original moisture source. A single wet wall cavity, left unaddressed, can seed an entire building.
Hidden Hotspots: The zones of highest risk are largely invisible during a routine walkthrough: wall cavities behind plumbing, crawl spaces and basement rim joists, attic sheathing beneath inadequate roof ventilation, and the interior lining of HVAC ducts. Visual inspection of living surfaces catches a fraction of total colonization.
Why Building Materials Matter: Modern construction materials are unusually hospitable to mold. Paper-faced drywall provides both a cellulose food source and a capillary surface for moisture retention. Engineered wood products and spray foam insulation installed against exterior walls can trap condensation with no drying pathway — creating a contained, dark, humid environment that functions as an ideal growth chamber.

1 — Bathroom Ceiling:
Warm shower steam rises and condenses against cooler ceiling surfaces. Without mechanical exhaust ventilation, relative humidity routinely exceeds 90% for extended periods after each use. The ceiling cavity above and the grout lines between tiles are the first surfaces to show active growth.
Common Species: Cladosporium, Aspergillus niger, Stachybotrys chartarum (chronic cases)
2 — Under the Kitchen Sink:
Slow pipe drips and drain condensation go unnoticed for weeks inside dark, enclosed cabinets.
The particleboard base — standard in most kitchen cabinetry — swells, retains moisture, and provides an ideal cellulose substrate. One of the most frequently discovered household mold sites during professional inspections.
Common Species: Penicillium, Aspergillus flavus, Trichoderma
3 — Laundry Area:
Washing machines generate sustained high humidity through the wash and dry cycle. Lint accumulation on surfaces provides organic material; poor venting traps moisture against walls. Front-loading machines are particularly prone to gasket mold, which can aerosolize spores into adjacent rooms during each cycle.
Common Species: Fusarium, Penicillium, Alternaria
4 — Bedroom Window Sill:
Cold glass surfaces cause warm indoor air to drop below its dew point, depositing condensation directly onto the sill and surrounding drywall. Often dismissed as a cosmetic issue, window sill colonization indicates chronic condensation that typically extends into the surrounding wall cavity.
Common Species: Cladosporium, Alternaria, Botrytis
5 — Living Room Wall Cavity:
Exterior wall cavities conceal slow leaks from failed flashing, cracked cladding, or inadequate window sealing. With no air circulation and a wood framing substrate, colonics can spread across an entire stud bay before any interior surface shows discoloration. Frequently undetected for months or years.
Common Species: Stachybotrys chartarum, Chaetomium globosum, Ulocladium
6 — HVAC Duct Lining:
Fiberglass duct lining provides both an organic substrate and insulating surface for condensation. Once colonized, the HVAC system becomes an active distribution mechanism — circulating spores to every room on the network with each heating or cooling cycle. A single contaminated duct section can affect areas.
Common Species: Aspergillus, Penicillium, Cladosporium
7 — Attic Sheathing
Warm, moist air from the living space rises and infiltrates the attic through ceiling penetrations and recessed lighting. When soffit and ridge ventilation is insufficient, this moisture condenses on cold roof sheathing through winter months. Attic mold is among the most common findings in home inspections and is frequently invisible from below.
Common species: Penicillium/Aspergillus complex, Cladosporium, Trichoderma
| Tier | Mechanism | Key Genera | Who’s at Risk |
|---|---|---|---|
| 1 — ALLERGEN | IgE‑mediated immune response; triggers allergies and asthma | Cladosporium, Alternaria | Anyone with mold allergy or asthma; general population at high enough levels |
| 2 — TOXIGENIC | Mycotoxin production; systemic effects beyond immune response | Aspergillus (some), Stachybotrys, Chaetomium, Penicillium (some) | General population at sufficient exposure; CIRS‑susceptible individuals especially |
| 3 — PATHOGENIC | Invasive fungal infection; spore germination in tissue | Aspergillus fumigatus, Fusarium | Primarily immunocompromised; can be fatal without antifungal treatment |

Found in 27% of indoor air tests; common on wet gypsum board, carpets, HVAC fans
Grows at cooler temperatures than most; first to appear after water intrusion
Potent asthma trigger and allergen; not generally toxigenic
Appears olive-green to black; suede-like texture
Found in 38% of all tested indoor air samples; 71% in basements
Wide risk range by species — some benign, some produce aflatoxin (human carcinogen; NTP 2021)
A. fumigatus causes ABPA in asthmatics; invasive aspergillosis in immunocompromised
Blue-green to white/gray; rapid spreader on multiple surfaces
Doesn’t require standing water; grows on minimal moisture — one of the hardest to prevent
Severe asthma exacerbation trigger; some cases life-threatening
Enters through windows and doors; thrives in bathrooms, around windows, on carpet
Dark gray to black spots; velvety texture
Found in 16% of indoor air tests; requires sustained cellulose saturation to establish
Produces trichothecene mycotoxins; strongest link to severe systemic effects
Typically found behind walls, under flooring after chronic leaks or flooding
See dedicated companion page for full clinical profile
Cellulose-digesting; particularly common after flooding events
Produces chaetoglobosin mycotoxins; linked to neurological symptoms in emerging research
Less studied than Stachybotrys but increasingly recognized as a clinical concern
Spreads rapidly on wet surfaces; one of the fastest-colonizing indoor molds
Both mycotoxin producer AND opportunistic pathogen — a rare dual-threat classification
Serious fungal infection risk in immunocompromised individuals; requires antifungal treatment
The biological chain from spore inhalation to systemic inflammation

Inhalation primary; spores bypass nasal filters. Dermal and ingestion secondary routes.

1–10 micron spores reach deep lung tissue. Mycotoxins bind to airborne particulate.

IgE-mediated (allergic), toxic, or infectious pathway activated depending on species and host.

Innate immune cascade; cytokine and chemokine storm with repeat exposure. Neural inflammation.

Respiratory, neurological, immunological, dermatological, or infectious outcomes by pathway.
Allergic: lgE-mediated; mast cell degranulation; histamine release; accounts for most mild-moderate presentations; reversible with avoidance
Toxic: Mycotoxins disrupt cellular function; inhibit protein synthesis; promote oxidative stress; dose-dependent; NOT IgE-mediated
Infectious: Spore germination in tissue; invasive fungal disease; primarily immunocompromised hosts; potentially fatal without treatment
2020 PMC Mouse Model Study: first controlled evidence that mold inhalation causes central neural effects via innate immune activation
Symptoms Indistinguishable: from bacterial/viral infection at the immune level — explains why mold illness is so often misdiagnosed
Proposed Mechanism: mycotoxin interference with neurotransmitter systems (AWMF 2024) (Why symptoms worsen with continued exposure and resolve with removal from the environment)

Organ-system breakdown with clinical diagnoses: The full spectrum from hay fever to hypersensitivity pneumonitis.
Allergic rhinitis: nasal congestion, sneezing, runny nose; most common presentation
Asthma: mold induces new-onset asthma in children; acute exacerbation trigger in adults; confirmed by NIEHS and multiple large studies
Hypersensitivity pneumonitis (HP): inflammatory lung disease; UT Southwestern 2025 — largest study ever linking home mold to HP; permanent lung scarring with chronic exposure
ABPA: severe Aspergillus-driven airway inflammation; primarily asthmatics and cystic fibrosis patients
Invasive pulmonary aspergillosis: life-threatening; spore germination in lung tissue; immunocompromised only
Brain Fog: short-term memory loss, difficulty concentrating, linked to mycotoxin neuroinflammation (NIEHS)
Sensory: blurred vision, balance disturbance, tinnitus, lightheadedness
Mood disorders: anxiety and depression formally recognized as mold sequelae (AWMF 2024 update)
Pain Syndromes: fibromyalgia and complex regional pain syndrome (CRPS) linked to mold in 2020 research
Mental Health Scale: Gatto et al. 2024 — depression, anxiety, stress elevated in adults and children in damp housing
Cytokine Dysregulation with Chronic Exposure: Promotes systemic low-grade inflammation
T-regulatory Cell Disruption mechanism underlying CIRS progression
Paradox: Mold simultaneously suppresses and hyperactivates immune function depending on exposure duration and genetic profile
Long-term Inhaled Mycotoxin Exposure may cause permanent immune system changes (NIEHS)
Eczema / Atopic Dermatitis: indoor mold during gestation and infancy linked to pediatric onset (WA Health / Australian research)
Eye Irritation: direct and systemic inflammatory pathways; redness, watering, itching
Sinusitis: allergic fungal sinusitis is a distinct clinical entity — not typical bacterial sinusitis
Cancer: aflatoxin classified as confirmed human carcinogen (NTP 2021); ochratoxin A under review
CIRS, sick building syndrome, cumulative toxin load; the most under-diagnosed health crisis in American housing.
A multisystem, multi-symptom biotoxin illness — and one of the most frequently misdiagnosed conditions in the U.S.
CIRS occurs when genetically susceptible individuals are exposed to water-damaged buildings. Their bodies cannot clear biotoxins normally, totally recirculate, sustained innate immune activation begins, and a cascade of systemic inflammation follows that looks like dozens of other conditions and is routinely missed by standard lab work.
25%
of population carries HLA-DR haplotype preventing normal biotoxin clearance160M
Americans estimated at potential CIRS risk (NIOSH building damage data)13
distinct symptom clusters used for diagnosis — 8+ required for positive screeningYears
average time to correct diagnosis — often misdiagnosed as CFS, fibromyalgia, anxiety